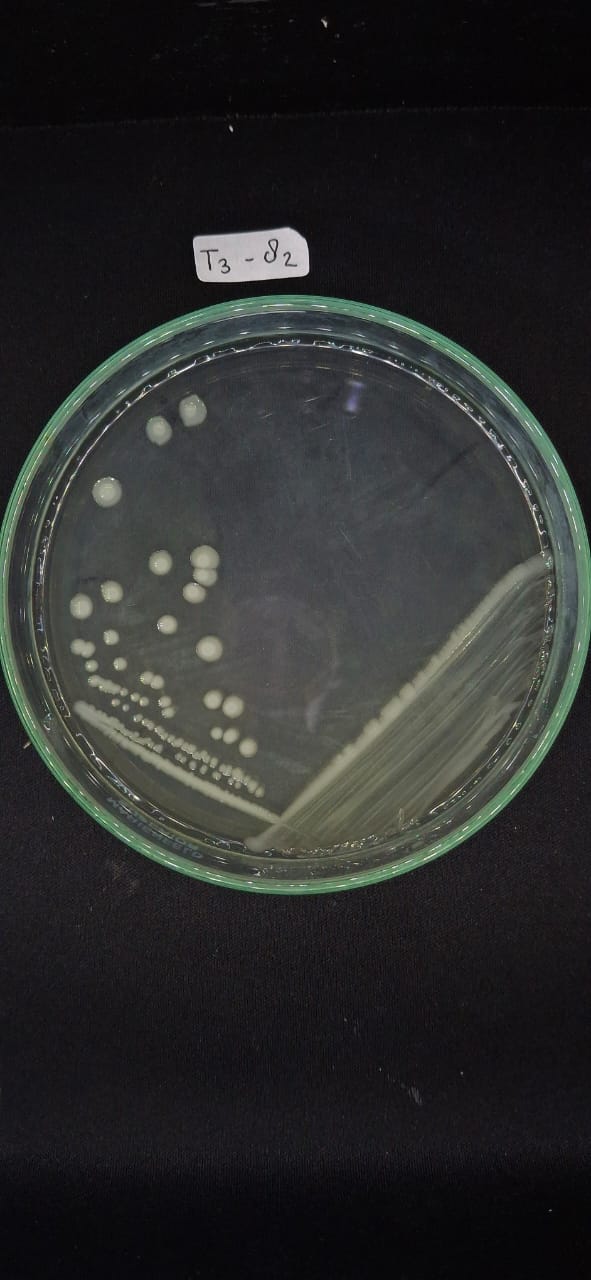

Penjualan Kultur Bakteri
Jurusan Biologi
Rp. 250.000
Spesifikasi Produk
–
Deskripsi Produk
Menjual Kultur Sel Bakteri
Ketersediaan
B. subtilis, S. aureus
Review Produk
Belum Tersedia
Kreativitas, Ilmu, dan Layanan Terbaik

Jurusan Biologi
Rp. 250.000
–
Menjual Kultur Sel Bakteri
B. subtilis, S. aureus
Belum Tersedia